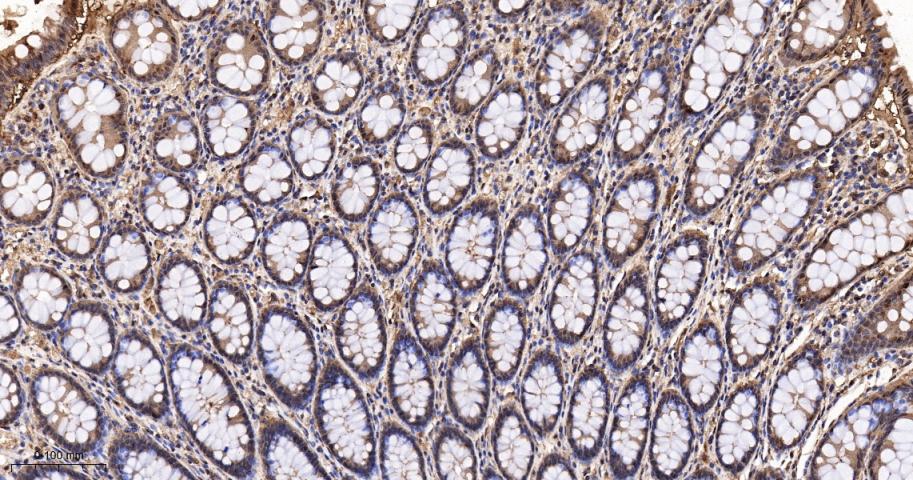
硫氧还蛋白重组兔单抗-bsm-63003R

Thioredoxin Recombinant Rabbit mAb (一抗) - WB,IHC-P,IHC-F,IF,ICC/IF,IP | Bioss
Rrmab?兔单抗

货号:bsm-63003R
产品详情
相关标记
相关产品
相关文献
常见问题
概述
产品编号
bsm-63003R
产品类型
重组兔单抗
英文名称
Thioredoxin Recombinant Rabbit mAb
中文名称
硫氧还蛋白重组兔单抗
英文别名
TRDX; TRX; TRX1; TXN1; Trx80; ADF; Txn; THIO_HUMAN; ATL-derived factor (ADF); Surface-associated sulphydryl protein (SASP); THIO_MOUSE; THIO_RAT;
抗体来源
Rabbit
免疫原
A synthesized peptide derived from human Thioredoxin: 1-55
亚型
IgG
性状
Liquid
纯化方法
affinity purified by Protein A
克隆类型
Recombinant
克隆号
2D20
理论分子量
12 kDa
检测分子量
11 kDa
储存液
10mM phosphate buffered saline(pH 7.4) with 150mM sodium chloride, 0.05% BSA, 0.02% Proclin300 and 50% glycerol.
研究领域
SWISS
Gene ID
保存条件
Store at 4℃ for short term. Store at -20℃ for long term. Avoid repeated freeze/thaw cycles.
注意事项
This product as supplied is intended for research use only, not for use in human, therapeutic or diagnostic applications.
数据库链接
产品介绍
硫氧还蛋白(Thioredoxin,Trx)是一类广泛存在于生物体内的多功能酸性蛋白,分子量约12kDa,是一种小分子含硒蛋白质,参与细胞的一系列生化反应,包括酶活性的调节、转录因子的调控等,是重要的酶活力调节蛋白。
硫氧还蛋白的功能绝大多数是依赖于硫氧还蛋白还原靶蛋白中的二硫键。所有硫氧还蛋白均有一个保守的活性中心,Trp-Cys-Gly(Ala)-Pro-Cys,活性中心有两个具有氧还活性的半胱氨酸残基。
硫氧还蛋白的功能绝大多数是依赖于硫氧还蛋白还原靶蛋白中的二硫键。所有硫氧还蛋白均有一个保守的活性中心,Trp-Cys-Gly(Ala)-Pro-Cys,活性中心有两个具有氧还活性的半胱氨酸残基。
背景资料
Participates in various redox reactions through the reversible oxidation of its active center dithiol to a disulfide and catalyzes dithiol-disulfide exchange reactions. Plays a role in the reversible S-nitrosylation of cysteine residues in target proteins, and thereby contributes to the response to intracellular nitric oxide. Nitrosylates the active site Cys of CASP3 in response to nitric oxide (NO), and thereby inhibits caspase-3 activity.

产品应用
| 应用 | 已检合格种属 | 预测种属 | 推荐稀释比例 |
|---|---|---|---|
| WB | Human | 1:500-2000 | |
| IHC-P | Human | 1:50-200 | |
| IHC-F | Human | 1:50-200 | |
| IF | Human | 1:50-200 | |
| ICC/IF | Human | 1:50-200 | |
| IP | Human | 1:20-50 |
交叉反应
交叉反应: Human
相关产品
暂无相关产品
靶标
基因名
TXN
蛋白名
Thioredoxin
亚基
Homodimer; disulfide-linked. Interacts with TXNIP through the redox-active site. Interacts with MAP3K5 and CASP3. In case of infection, interacts with S.typhimurium protein slrP. Interacts with APEX1; the interaction stimulates the FOS/JUN AP-1 DNA-binding activity in a redox-dependent manner.
亚细胞定位
Nucleus. Cytoplasm. Secreted. Note=Secreted by a leaderless secretory pathway. Predominantly in the cytoplasm in non irradiated cells. Radiation induces translocation of TRX from the cytoplasm to the nucleus.
相似性
Belongs to the thioredoxin family. Contains 1 thioredoxin domain.
功能
Participates in various redox reactions through the reversible oxidation of its active center dithiol to a disulfide and catalyzes dithiol-disulfide exchange reactions. Plays a role in the reversible S-nitrosylation of cysteine residues in target proteins, and thereby contributes to the response to intracellular nitric oxide. Nitrosylates the active site Cys of CASP3 in response to nitric oxide (NO), and thereby inhibits caspase-3 activity. Induces the FOS/JUN AP-1 DNA-binding activity in ionizing radiation (IR) cells through its oxidation/reduction status and stimulates AP-1 transcriptional activity.
同靶标产品
相关文献
提示: 发表研究结果有使用 bsm-63003R 时请让我们知道,以便我们可以引用参考文章。作为回馈,资料提供者将获得我们送上的小礼品。